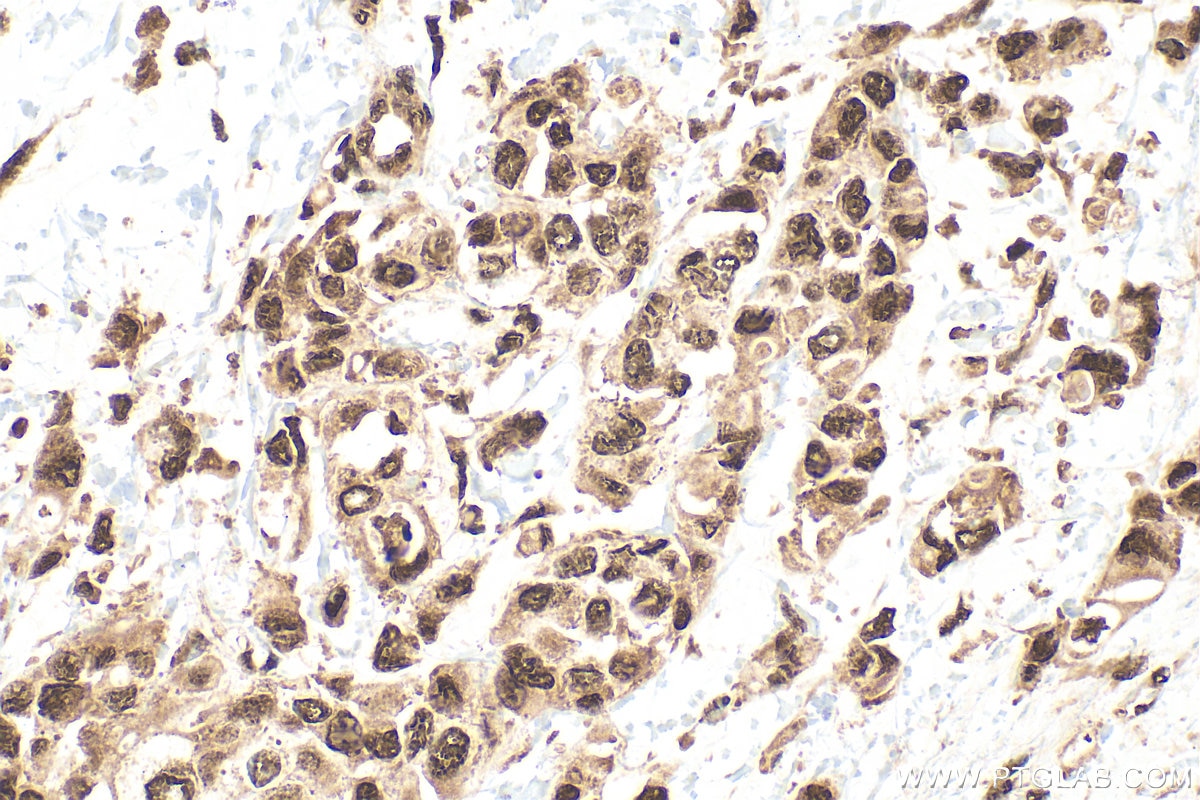
IHC staining of human breast cancer using 10829-1-AP Immunohistochemistry (IHC) staining of human breast cancer tissue using HMGB1 Polyclonal antibody (10829-1-AP)

Tested Applications
| Positive WB detected in | HeLa cells, Jurkat cells, NIH/3T3 cells, C6 cells, RAW264.7 cells, mouse kidney tissue, rat kidney tissue |
| Positive IHC detected in | mouse brain tissue, human breast cancer tissue, human colon tissue Note: suggested antigen retrieval with TE buffer pH 9.0; (*) Alternatively, antigen retrieval may be performed with citrate buffer pH 6.0 |
| Positive IF/ICC detected in | HEK-293 cells, U2OS cells |
Recommended dilution
| Application | Dilution |
|---|---|
| Western Blot (WB) | WB : 1:5000-1:50000 |
| Immunohistochemistry (IHC) | IHC : 1:50-1:500 |
| Immunofluorescence (IF)/ICC | IF/ICC : 1:200-1:800 |
| It is recommended that this reagent should be titrated in each testing system to obtain optimal results. | |
| Sample-dependent, Check data in validation data gallery. | |
Product Information
10829-1-AP targets HMGB1 in WB, IHC, IF/ICC, IP, CoIP, ChIP, RIP, ELISA applications and shows reactivity with human, mouse, rat samples.
| Tested Reactivity | human, mouse, rat |
| Cited Reactivity | human, mouse, rat, zebrafish |
| Host / Isotype | Rabbit / IgG |
| Class | Polyclonal |
| Type | Antibody |
| Immunogen |
CatNo: Ag1264 Product name: Recombinant human HMGB1 protein Source: e coli.-derived, PGEX-4T Tag: GST Domain: 1-215 aa of BC003378 Sequence: MGKGDPKKPRGKMSSYAFFVQTCREEHKKKHPDASVNFSEFSKKCSERWKTMSAKEKGKFEDMAKADKARYEREMKTYIPPKGETKKKFKDPNAPKRPPSAFFLFCSEYRPKIKGEHPGLSIGDVAKKLGEMWNNTAADDKQPYEKKAAKLKEKYEKDIAAYRAKGKPDAAKKGVVKAEKSKKKKEEEEDEEDEEDEEEEEDEEDEDEEEDDDDE Predict reactive species |
| Full Name | high-mobility group box 1 |
| Calculated Molecular Weight | 25 kDa |
| Observed Molecular Weight | 25-30 kDa |
| GenBank Accession Number | BC003378 |
| Gene Symbol | HMGB1 |
| Gene ID (NCBI) | 3146 |
| RRID | AB_2232989 |
| Conjugate | Unconjugated |
| Form | Liquid |
| Purification Method | Antigen affinity purification |
| UNIPROT ID | P09429 |
| Storage Buffer | PBS with 0.02% sodium azide and 50% glycerol, pH 7.3. |
| Storage Conditions | Store at -20°C. Stable for one year after shipment. Aliquoting is unnecessary for -20oC storage. 20ul sizes contain 0.1% BSA. |
Background Information
The HMG (high mobility group) proteins are nonhistone chromosomal proteins that is present in almost all eukaryotic cells, and it functions to stabilize NUCLEOSOME formation and acts as a transcription-factor-like protein that regulates the expression of several genes[PMID: 18160415]. Once injury, infection or other inflammatory stimuli, activated macrophages, mature dendritic cells and natural killer cells can secret HMGB1, which act as a crucial cytokine[PMID: 20163887]. HMGB1 also involved in V(D)J recombination by acting as a cofactor of the RAG complex, stimulating cleavage and RAG protein binding at the 23 bp spacer of conserved recombination signal sequences (RSS)[PMID: 19360789 ]. Act as a Heparin-binding protein that has a role in the extension of neurite-type cytoplasmic processes in developing cells. HMGB1 (high mobility group box 1) modulates gene expression in the nucleus, but certain immune cells secrete HMGB1 as an extracellular Alarmin to signal tissue damage.The nuclear HMGB1 relocalizes to the extracellular milieu in senescent human and mouse cells in culture and in vivo, which stimulated cytokine secretion through TLR-4 signaling (23649808).This antibody is a rabbit polyclonal antibody raised against full length HMGB1 of human origin. HMGB1 was oxidized to Ox-HMGB1 at mild ROS concentrations and finally to Di-HMGB1(58 kDa) at excessive ROS concentrations (PMID: 33461096).
Protocols
| Product Specific Protocols | |
|---|---|
| IF protocol for HMGB1 antibody 10829-1-AP | Download protocol |
| IHC protocol for HMGB1 antibody 10829-1-AP | Download protocol |
| WB protocol for HMGB1 antibody 10829-1-AP | Download protocol |
| Standard Protocols | |
|---|---|
| Click here to view our Standard Protocols |
Publications
| Species | Application | Title |
|---|---|---|
ACS Nano Tumor-Acidity and Bioorthogonal Chemistry-Mediated On-Site Size Transformation Clustered Nanosystem to Overcome Hypoxic Resistance and Enhance Chemoimmunotherapy. | ||
ACS Nano Mitochondria-Targeting Polymer Micelle of Dichloroacetate Induced Pyroptosis to Enhance Osteosarcoma Immunotherapy. | ||
ACS Nano Nanointegrative In Situ Reprogramming of Tumor-Intrinsic Lipid Droplet Biogenesis for Low-Dose Radiation-Activated Ferroptosis Immunotherapy | ||
Sci Adv One-dimensional nanosonosensitizer boosted multiple branches of immune responses against MHC-deficient immune-evasive urologic tumor | ||
Nat Commun Engineered macrophages as near-infrared light activated drug vectors for chemo-photodynamic therapy of primary and bone metastatic breast cancer. |
Reviews
The reviews below have been submitted by verified Proteintech customers who received an incentive for providing their feedback.
FH Gaurav (Verified Customer) (02-27-2026) | Works with a variety of cell lysates
|
FH Vignesh (Verified Customer) (11-12-2025) | excellent
|
FH Chun (Verified Customer) (06-19-2022) | This antibody worked well.
|
FH PATRICK (Verified Customer) (12-01-2018) | This antibody worked well. ProteinTech provides antibody specific instructions that were helpful for each of the antibodies we ordered.
|